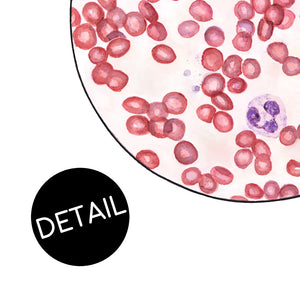

Fine Art Print
A microscopic view of a blood smear.
Fine art giclee prints are created using museum quality, archival materials. With a professional Canon imagePROGRAF photography printer, vibrant pigment inks are deposited onto lush Somerset Velvet, 100% cotton rag paper. The lightly textured heavy weight paper gives the look and feel of an original watercolor painting, and with the archival longevity of up to 200 years!
Each and every print is created, signed, and shipped from the studio.